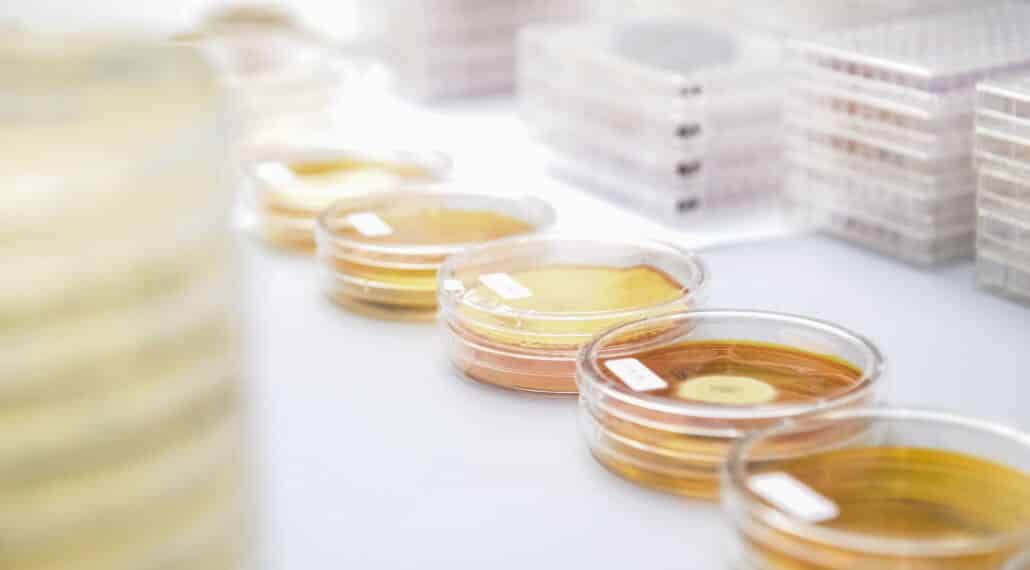

Domatec GmbH
Mühlbauerstraße 6,
84453 Mühldorf am Inn
- Trinkwasser
- Badewässer / Schwimmbäder
- Luftqualität
- Lüftungsanlagen
- Prüfung der Umgebungsluft
- Wasserversorger
- Hausverwaltungen
- Facility management
- Hotellerie
- Gesundheitsbranche
AKKREDITIERUNG
- DIN EN ISO/IEC 17025:2005
domatec ist ein akkreditiertes Prüflabor nach DIN EN ISO/IEC 17025:2005 und zugelassene Untersuchungsstelle nach § 15 Trinkwasserverordnung.
Die Firma domatec bietet mit Niederlassungen in ganz Deutschland ein breites Spektrum von Analysen und Ingenieurleistungen im Bereich Wasser und Luft an. Das Leistungsspektrum beinhaltet im Bereich Wasser mikrobiologische und chemische Analysen von Roh- und Trinkwasser gemäß Trinkwasserverordnung, von Schwimm- und Badebeckenwasser gemäß DIN EN ISO 19643 Teil 1, von Wasser aus Verdunstungskühlanlagen, Kühltürmen und Nassabscheidern gemäß 42. BImSchV, VDI 2047 Blatt 2 und 3, VDI 3803 Blatt 2 sowie von Wasser aus Raumlufttechnischen Anlagen gemäß VDI 6022 Blatt 1. Im Bereich der Lufthygiene werden unter anderem qualifizierte Auswertungen von Abklatsch- und Tupferproben für raumlufttechnische Anlagen nach VDI 6022 Blatt 1 sowie von Verdunstungskühlanlagen nach VDI 2047 Blatt 2 und Blatt 3 und 42. BImSchV (Verordnung über Verdunstungskühlanlagen, Kühltürme und Nassabscheider) durchgeführt. Ergänzt wird der Untersuchungsumfang von Schimmelpilzuntersuchungen von Innenraumluft nach der Normenreihe DIN EN ISO 16000, Staubflächendichteuntersuchungen in raumlufttechnischen Anlagen nach DIN EN 15780 und VDI 6022 Blatt 1 sowie der Untersuchungen von Material-, Oberflächen- oder Luftproben auf Mykotoxine und Endotoxine.
Zertifizierte Experten führen Hygieneinspektionen und Gefährdungsanalysen durch.
Das rundum Service-Paket der domatec wird durch Schulungen im Bereich Wasser- und Lutfhygiene z.B. nach VDI Richtlinie 6023 abgerundet.